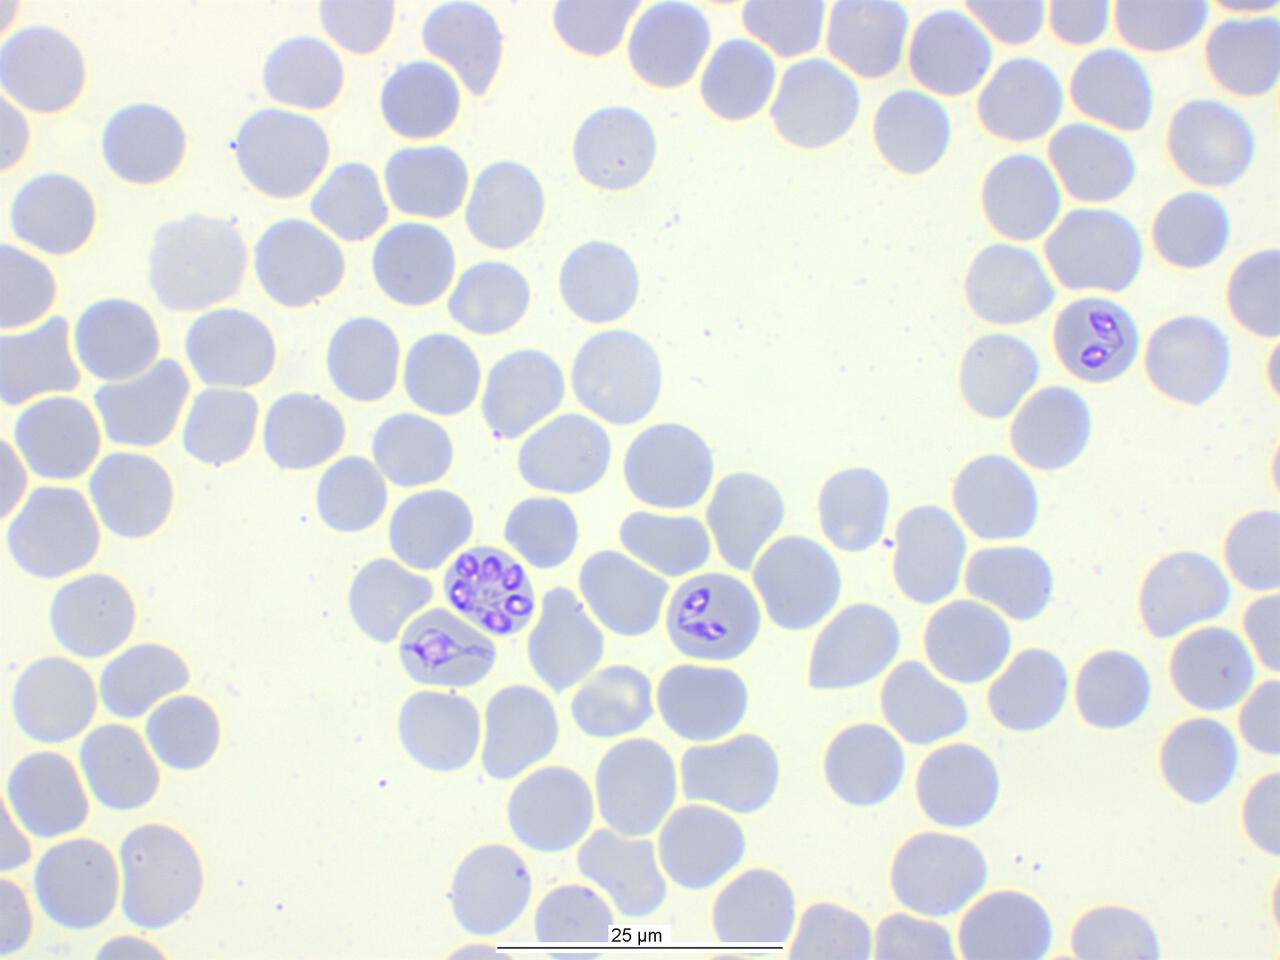

Mikroskopisch klein und doch so gefährlich!
Die einst als Mittelmeererkrankung bekannte Babesiose (Hundemalaria) gibt es jetzt auch häufig bei uns.
Eine infizierte Zecke kann diesen Blutparasiten übertragen. Der Parasit befällt die roten Blutkörperchen des Hundes, dies führt zur Blutarmut. In seltenen Fällen kann die Blutarmut so stark sein, dass eine Blutspende benötigt wird.
Symptome sind Fieber, Unwohlsein, Appetitslosigkeit, blasse Schleimhäute und eventuell auch schon blutiger Urin. Sollte Ihr Hund diese Symptome aufweisen, stellen Sie ihn umgehend einem Tierarzt vor.
Um der Babesiose vorzubeugen, raten wir Ihnen, regelmäßig eine gegeignete Zeckenprophylaxe durchzuführen. Sie können sich gern bei uns beraten lassen.